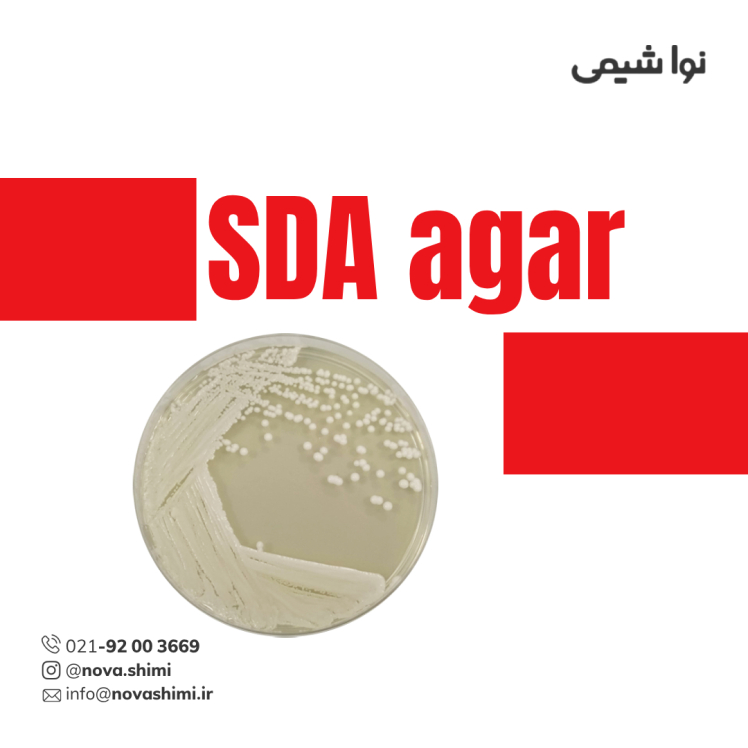
محیط کشت سابرو دکستروز آگار (SDA) مرک (GranuCult® prime SDA)

محیط کشت بلاد آگار مرک (Blood Agar)
مشخصات فنی محیط کشت BA:
1. برند: Merck Millipore
2. کاربرد: محیط کشت میکروبی
3. فرم فیزیکی: پودر (Powder)
4. حجم بسته: 500 گرم
محیط کشت بلاد آگار چیست؟
محیط کشت بلاد آگار (Blood Agar) برای رشد باکتریهای سختپرور و تشخیص همولیز، مناسب صنایع غذایی و داروسازی، با کیفیت بالا و پودر آماده ترکیب است. شرکت نُـواشیمی، به عنوان یکی از تامین کنندگان مواد آزمایشگاهی و محیط کشت برند مرک و سیگما آلدریچ، آماده ارائه خدمات فروش محیط کشت بلاد آگار مرک کد 103879 به شما عزیزان خواهد بود. برای دریافت اطلاعات فنی و استعلام قیمت محیط کشت بلاد آگار مرک، از طریق شماره 02192003669 با کارشناسان فروش نُـوا شیمی تماس حاصل فرمایید.
برای آشنایی بیشتر با ویژگیها و مشخصات محصول، میتوانید با کلیک روی هر عنوان، به توضیحات تکمیلی در زیرعنوانهای مربوطه دسترسی پیدا کنید.
مشخصات محصول (Product Specifications)
مشخصات فنی محیط کشت بلاد آگار مرک (Product Specifications)
در جدول زیر میتوانید مشخصات فنی کامل محیط کشت بلاد آگار مرک (GranuCult® plus) را مشاهده کنید.
ویژگی | توضیح |
|---|---|
کیفیت (Quality Level) | 200 |
فرم (Form) | Powder |
pH (25°C) | 6.8 ± 0.2 |
تکنیکها (Technique(s)) | مناسب برای شناسایی میکروبها و تشخیص آنزیمهای خاص |
کاربرد (Application(s)) | صنایع غذایی و داروسازی |
شرایط نگهداری (Storage temp.) | 15-25°C |
گونههای مناسب (Suitability) | Enterococcus spp., Haemophilus spp., Pneumococcus spp., Staphylococcus spp., Streptococcus spp. |
برای مشاهده اطلاعات کامل محصول در سایت مرک و جزئیات کاربردی آن، بر روی Blood Agar کلیک کنید. شرکت نُـوا شیمی، تأمینکننده انواع محیط کشت برندهای معتبر مانند مرک و سیگما آلدریچ است و امکان خرید آسان و مطمئن این محصولات آزمایشگاهی را برای شما فراهم میکند.
آنالیز و کیفیت (Analysis Note)
ویژگیهای آنالیزی و کیفیت (Analysis Note)
Appearance (clearness): پودر همگن، بدون ذرات خارجی و قابل حل شدن کامل
Appearance (colour): کرم روشن تا قهوهای روشن
pH-value (25°C, 40 g/L in H₂O, after autoclaving): بر حسی سانتیگراد 6.6 – 7.0
Growth promotion test: مطابق با استانداردهای میکروبیولوژی مواد غذایی و نسخههای ISO/EP/USP/JP
Recovery rate: ≥ 70% برای گونههای Enterococcus spp., Staphylococcus aureus, Streptococcus spp.
Growth support: رشد سریع و کامل باکتریهای سختپرور، مناسب برای مشاهده همولیز
جدول راهنمای ویژگیهای آنالیزی محیط کشت بلاد آگار
| ویژگی | توضیح کامل | |
|---|---|---|
| شکل ظاهری (Appearance - clearness) | پودر محیط کشت بلاد آگار پس از حل شدن در آب و آمادهسازی، شفاف و همگن است. این ویژگی نشاندهنده کیفیت بالای پودر و عدم وجود ذرات معلق یا ناخالصی است. | |
| رنگ (Appearance - colour) | رنگ محیط کرم روشن تا قهوهای روشن است. رنگ طبیعی و استاندارد محیط نشاندهنده ترکیب مناسب مواد مغذی و شرایط تولید صحیح است. | |
| pH-value (25°C, 40 g/L in H₂O, after autoclaving) | مقدار pH بین 6.6 تا 7.0 است. pH مناسب باعث رشد انتخابی باکتریهای سختپرور و حفظ شرایط ایدهآل میکروبی میشود. | |
| تست رشد (Growth promotion test) | محیط مطابق با استانداردهای ISO، EP، USP و JP تست میشود تا قابلیت پرورش گونههای استاندارد باکتریایی تضمین شود. | |
| درصد بازیابی (Recovery rate) | بازیابی ≥70٪ کلونیها برای Enterococcus spp., Staphylococcus aureus و Streptococcus spp. نشاندهنده توانایی محیط در حمایت از رشد باکتریهای سختپرور است. | |
| رشد باکتریها (Growth support) | محیط رشد سریع و کامل باکتریهای سختپرور را فراهم میکند و امکان مشاهده همولیز و الگوهای آن را به دقت فراهم مینماید. | |
| زمان و دمای انکوباسیون (Incubation) | دمای پیشنهادی 35-37°C و مدت زمان 24-48 ساعت برای مشاهده رشد بهینه و همولیز کافی است. |
خرید محیط کشت بلاد آگار مرک (GranuCult® plus Blood Agar (BA) Base)
خرید محیط کشت بلاد آگار مرک (GranuCult® plus Blood Agar (BA) Base) کد 103879
محیط کشت بلاد آگار (Blood Agar) یک محیط کشت غنی و مغذی است که برای رشد باکتریهای سختپرور و بررسی واکنشهای همولیتیک طراحی شده است. این محیط با ترکیب عصاره قلب و پپتون، منابع نیتروژن، کربن، آمینو اسیدها و ویتامینهای مورد نیاز باکتریها را فراهم میکند و آگار به عنوان عامل سفتکننده عمل میکند. پس از اضافه کردن خون بدون فیبرین، محیط قادر است الگوهای همولیز گونههای مختلف از جمله Enterococcus spp., Staphylococcus spp. و Streptococcus spp. را به وضوح نشان دهد. محیط کشت بلاد آگار برای استفاده در آزمایشهای میکروبیولوژی غذایی، دارویی و بالینی مناسب بوده و رشد سریع و کامل باکتریهای هدف را تضمین میکند.
این محصول، با کیفیت GranuCult® plus و کنترل دقیق، سطح استاندارد بالایی از بازیابی و قابلیت اطمینان در آزمایشها ارائه میدهد.
کمپانی مِرک (MERCK)
شرکت مرک (Merck KGaA) یکی از قدیمیترین و معتبرترین کمپانیهای علمی و فناوری در جهان است که در سال 1668 در آلمان تأسیس شد و امروزه بهعنوان پیشگام جهانی در حوزههای مواد شیمیایی آزمایشگاهی، بیوتکنولوژی و داروسازی شناخته میشود. بخش مواد آزمایشگاهی مرک، طیف گستردهای از مواد شیمیایی با گریدهای مختلف از جمله آنالیتیکال، ACS، HPLC، و Suprapur® را ارائه میدهد که برای تحقیقات علمی، کنترل کیفیت صنعتی، و مصارف آموزشی کاربرد دارند.
شرکت نُـوا شیمی، تامین کننده مواد آزمایشگاهی محیط کشت
شرکت نُـوا شیمی، با سابقهای درخشان در تامین مواد آزمایشگاهی، استاندارد ها و تجهیزات آزمایشگاه، با دسترسی گسترده به محصولات برندهای معتبر داخلی و بینالمللی، تامین نیازهای صنایع، آزمایشگاههای تحقیقاتی و داروسازی را با رویکردی مدرن و دقیق دنبال میکند. در صورت نیاز به استعلام قیمت محیط کشت بلاد آگار مرک کد 103879 یا سایر مواد آزمایشگاهی، استاندارد و رفرنسهای آزمایشگاهی کارشناسان ما از طریق خط ویژه 02192003669 آماده پاسخگویی و ارائه مشاوره تخصصی به شما خواهند بود.
کاربرد های محیط کشت بلاد آگار
مهمترین کاربردهای محیط کشت بلاد آگار:
در ادامه، کاربردهای محیط کشت بلاد آگار مرک را مطالعه خواهیم نمود:
1. جداسازی باکتریهای سختپرور
محیط کشت بلاد آگار برای رشد و جداسازی باکتریهای سختپرور مانند Enterococcus spp., Haemophilus spp., Pneumococcus spp., Staphylococcus spp. و Streptococcus spp. استفاده میشود. این محیط با فراهم کردن مواد مغذی کامل و خون بدون فیبرین، رشد این میکروارگانیسمها را بهینه میکند.
2. تعیین واکنشهای همولیتیک
یکی از کاربردهای اصلی محیط کشت بلاد آگار، شناسایی الگوهای همولیز باکتریها است. پس از اضافه کردن خون، محیط کشت بلاد آگار امکان مشاهده همولیز آلفا، بتا و گاما را فراهم میکند که برای تشخیص گونههای مختلف میکروبها ضروری است.
3. استفاده در آزمایشگاههای غذایی و دارویی
محیط کشت بلاد آگار به طور گسترده در آزمایشهای کنترل کیفیت مواد غذایی و دارویی به کار میرود تا رشد باکتریها و بررسی واکنشهای همولیتیک انجام شود و سلامت محصولات تضمین گردد.
4. کاربرد در تحقیقات بالینی و تشخیص پزشکی
در آزمایشگاههای بالینی، محیط کشت بلاد آگار برای کشت نمونههای بالینی و شناسایی باکتریهای پاتوژن از جمله استرپتوکوکها و استافیلوکوکها استفاده میشود. این محیط امکان بررسی سریع و دقیق رشد و همولیز را فراهم میکند.
5. ارزیابی کیفیت نمونهها و مطالعه میکروبیولوژیکی
محیط کشت بلاد آگار به دلیل ترکیب غنی و خون اضافه شده، برای ارزیابی کیفیت نمونهها و مطالعه رشد میکروارگانیسمها و تعامل آنها با محیط مناسب است و در تحقیقات علمی و کنترل کیفی کاربرد دارد.
برای دریافت استعلام قیمت محیط کشت بلاد آگار مرک کد 103879، لطفا با شماره 02192003669 تماس حاصل فرمایید. کارشناسان ما آماده پاسخگویی به سوالات شما هستند.
نکات ایمنی
نکات ایمنی و نگهداری (Safety & Storage)
در ادامه نکات ایمنی استفاده از محیط کشت بلاد آگار (Blood Agar) برند مرک را مطالعه خواهیم نمود:
ویژگی ایمنی | توضیح کامل |
|---|---|
کد کلاس ذخیرهسازی (Storage Class Code) | 11 – مواد جامد قابل اشتعال. این بدان معناست که محیط کشت باید از منابع حرارتی و شعله مستقیم دور نگه داشته شود. |
WGK | WGK 3 – محیط با ریسک متوسط تا بالا برای آبها که نیازمند مدیریت مناسب در انبارداری و دفع است. |
نماد خطر (Pictogram) | علامت هشدار (Exclamation mark) نشاندهنده احتمال حساسیت پوستی یا تحریک است. |
کلاس خطر | حساسیت پوستی سطح 1 (Skin Sens. 1) – تماس مستقیم با پوست میتواند باعث واکنش آلرژیک شود. |
کلمات هشدار (Signal Word) | Warning – هشدار دهنده کاربر نسبت به احتمال ایجاد حساسیت پوستی یا تحریک. |
اقدامات احتیاطی (Precautionary Statements) | - P261: از استنشاق گرد و غبار خودداری شود.- P272: از لباس محافظ مناسب استفاده شود.- P280: دستکش و محافظ چشم و صورت بپوشید.- P302 + P352: در صورت تماس با پوست، با آب و صابون شستشو دهید.- P333 + P313: در صورت بروز تحریک یا واکنش پوستی، به پزشک مراجعه کنید.- P362 + P364: لباس آلوده را درآورده و شستشو دهید. |
ذخیرهسازی و محافظت | محیط کشت بلاد آگار باید در بستهبندی اصلی، در جای خشک و خنک (15-25°C) نگهداری شود و از تابش مستقیم نور خورشید و رطوبت محافظت گردد. |
استفاده آزمایشگاهی | فقط برای کاربردهای in vitro؛ تماس با محیط باز یا بلعیده شدن خطرناک است و باید از قرار دادن در محیطهای عمومی خودداری شود. |
اگر به دنبال محیط کشت بلاد آگار (Blood Agar) هستید، نُـوا شیمی همراهی مطمئن در مسیر تامین نیاز های شما خواهد بود. برای سفارش، دریافت مشاوره فنی و آگاهی از شرایط همکاری؛ از طریق شماره 02192003669 با تیم فروش در ارتباط باشید.
سوالات متداول (FAQ)
سوالات متداول درباره محیط کشت بلاد آگار مرک (FAQ)
1. محیط کشت بلاد آگار چیست و چه کاربردی دارد؟
محیط کشت بلاد آگار یک محیط غنی و مغذی است که برای رشد میکروارگانیسمهای سختپرورش (fastidious) و تعیین الگوی همولیز کلونیها استفاده میشود. این محیط امکان شناسایی باکتریهای همولیتیک را فراهم میکند.
2. آیا محیط کشت بلاد آگار آماده استفاده است یا نیاز به آمادهسازی دارد؟
محصول به صورت پودر عرضه میشود و پس از حل شدن و اتوکلاو، آماده افزودن خون و استفاده در آزمایشگاه است.
3. چه باکتریهایی در محیط کشت بلاد آگار رشد میکنند؟
این محیط برای باکتریهای fastidious مانند Enterococcus spp.، Haemophilus spp.، Pneumococcus spp.، Staphylococcus spp. و Streptococcus spp. مناسب است.
4. دمای نگهداری محیط کشت بلاد آگار چقدر است؟
محیط باید در جای خشک و خنک، بین 15 تا 25 درجه سانتیگراد نگهداری شود و از نور مستقیم خورشید و رطوبت محافظت گردد.
5. آیا محیط کشت بلاد آگار برای تستهای همولیز مناسب است؟
بله، با افزودن خون دفیبرینه، محیط امکان تعیین همولیز α، β و γ کلونیها را فراهم میکند.
6. اقدامات ایمنی هنگام استفاده از محیط کشت چیست؟
باید از تماس با پوست و استنشاق گرد و غبار خودداری کرد، دستکش و محافظ چشم استفاده شود و لباسهای آلوده شسته شوند.
7. چه مدت پس از آمادهسازی میتوان محیط را استفاده کرد؟
پس از آمادهسازی و افزودن خون، محیط باید به سرعت مصرف شود و نگهداری طولانی مدت توصیه نمیشود.

هنوز نظری ثبت نشده
اولین نفری باشید که نظر میدهید
ثبت نظر